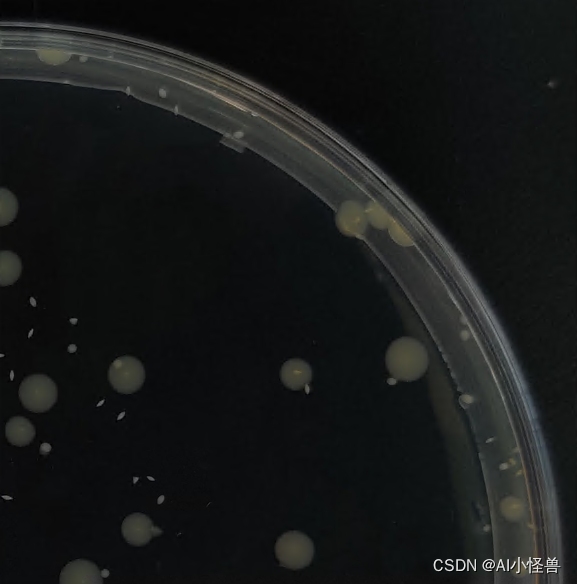

目录
自我介绍
希望您持续关注AI小怪兽的不断进化、打怪!!!
AI小怪兽:1)YOLO骨灰级玩家,YOLOv5、v7、v8优化创新,复现计算机视觉顶会,创新科研涨点小能手;2)就职于智能制造与数智创新企业,工业界项目落地、部署经验丰富,为半导体、3C等行业部署过几十个项目;

时间轴
第一篇基于YOLOv5的绝缘子检测,当初只是想简单记录一下,并没有想过在CSDN创作的想法


后续断断续续在CSDN更新过几篇(主要还是记录为主,项目级别实战为主)

2023年3月13日 正式在CSDN进行创作

收获
在创作的过程中都有哪些收获?
- 获得了14000+粉丝,其中2600+铁粉(感谢各位的关注);
- 共发表375篇博客,其中369篇发表于2023年;
- 所有博客,算是一种积累、记录吧,在工作中AI小怪兽也会翻看自己的博客快速进行项目开展;
- 认识了一些志同道合的好友,也拓展了自己的视野和认知;

5.杭州原力榜第1名,全站原力榜第7名


日常
当前创作和你的工作、学习是如何的结合
- 创作已经是你生活的一部分了,模型的魔改在日常项目中取得精度的提升,也会第一时间发表在博客中;

成就
最近部署的项目举例展开? 请用代码块贴出来
在某客户工业缺陷检测项目中,要求:1)GPU C++部署;2)检测准确度99%以上,单张推理耗时≤80ms,难点样本数量少,检测缺陷为小目标检测
检测目标
部署方案:多头检测器+大小缺陷一网打尽GiraffeDet+Wasserstein Distance Loss,助力工业缺陷检测,大幅提升产线检测能力
| layers | parameters | GFLOPs | mAP50 | mAP50-95 | ||
| paper | YOLOv8n | 168 | 3005843 | 8.1 | 0.936 | 0.772 |
| YOLOv8-goldYOLO | 359 | 6015123 | 11.9 | 0.945 | 0.787 | |
| YOLOv8n_smallobject _CSPStage +Wasserstein loss | 303 | 2953396 | 12.5 | 0.955 | 0.811 |
核心代码:
# Ultralytics YOLO 🚀, GPL-3.0 license
# YOLOv8 object detection model with P3-P5 outputs. For Usage examples see https://docs.ultralytics.com/tasks/detect
# Parameters
nc: 1 # number of classes
scales: # model compound scaling constants, i.e. 'model=yolov8n.yaml' will call yolov8.yaml with scale 'n'
# [depth, width, max_channels]
n: [0.33, 0.25, 1024] # YOLOv8n summary: 225 layers, 3157200 parameters, 3157184 gradients, 8.9 GFLOPs
s: [0.33, 0.50, 1024] # YOLOv8s summary: 225 layers, 11166560 parameters, 11166544 gradients, 28.8 GFLOPs
m: [0.67, 0.75, 768] # YOLOv8m summary: 295 layers, 25902640 parameters, 25902624 gradients, 79.3 GFLOPs
l: [1.00, 1.00, 512] # YOLOv8l summary: 365 layers, 43691520 parameters, 43691504 gradients, 165.7 GFLOPs
x: [1.00, 1.25, 512] # YOLOv8x summary: 365 layers, 68229648 parameters, 68229632 gradients, 258.5 GFLOPs
# YOLOv8.0s backbone
backbone:
# [from, repeats, module, args]
- [-1, 1, Conv, [64, 3, 2]] # 0-P1/2
- [-1, 1, Conv, [128, 3, 2]] # 1-P2/4
- [-1, 3, C2f, [128, True]]
- [-1, 1, Conv, [256, 3, 2]] # 3-P3/8
- [-1, 6, C2f, [256, True]]
- [-1, 1, Conv, [512, 3, 2]] # 5-P4/16
- [-1, 6, C2f, [512, True]]
- [-1, 1, Conv, [1024, 3, 2]] # 7-P5/32
- [-1, 3, C2f, [1024, True]]
- [-1, 1, SPPF, [1024, 5]] # 9
# YOLOv8.0s head
head:
- [-1, 1, nn.Upsample, [None, 2, 'nearest']]
- [[-1, 6], 1, Concat, [1]] # cat backbone P4
- [-1, 3, CSPStage, [512]] # 13
- [-1, 1, nn.Upsample, [None, 2, 'nearest']]
- [[-1, 4], 1, Concat, [1]] # cat backbone P3
- [-1, 3, CSPStage, [256]] # 17 (P3/8-small)
- [-1, 1, nn.Upsample, [None, 2, 'nearest']]
- [[-1, 2], 1, Concat, [1]] # cat backbone P3
- [-1, 3, CSPStage, [128]] # 20 (P4/16-medium)
- [-1, 1, Conv, [256, 3, 2]]
- [[-1, 15], 1, Concat, [1]] # cat head P4
- [-1, 3, CSPStage, [256]] # 20 (P4/16-medium)
- [-1, 1, Conv, [512, 3, 2]]
- [[-1, 12], 1, Concat, [1]] # cat head P5
- [-1, 3, CSPStage, [512]] # 23 (P5/32-large)
- [-1, 1, Conv, [512, 3, 2]]
- [[-1, 9], 1, Concat, [1]] # cat head P5
- [-1, 3, CSPStage, [1024]] # 23 (P5/32-large)
- [[18, 21, 24,27], 1, Detect, [nc]] # Detect(P3, P4, P5)详见:基于YOLOv8的端面小目标计数解决方案: 多头检测器+小缺陷到大缺陷一网打尽的GiraffeDet+Wasserstein Distance Loss | 助力工业小目标缺陷检测-CSDN博客
憧憬
希望您继续持续关注AI小怪兽的不断进化、打怪!!!
会在CSDN持续创作,分享1)YOLOv5、v7、v8优化创新,复现计算机视觉顶会,创新科研;2)项目中实战经验和不同环境部署(主要是C++和C#);
YOLOv5、v7、v8各个专栏会持续更新下去
强烈推荐以下专栏:
YOLOv5/YOLOv7魔术师:http://t.csdn.cn/ZjdwA
YOLOv8魔术师:http://t.csdn.cn/cGMj2
YOLOv7高阶自研: http://t.csdnimg.cn/drage
YOLOv5/YOLOv7/YOLOv8最新改进大作战:http://t.csdn.cn/ZkgsM
YOLO小目标检测:http://t.csdn.cn/9VysZ
Tips

























 1205
1205

 被折叠的 条评论
为什么被折叠?
被折叠的 条评论
为什么被折叠?










